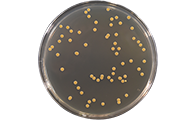
菌落总数

菌落总数不合格的原因分析,如何预防?
发布时间:2022-04-01 浏览次数:4162
一、菌落总数(aerobic plate count)定义●●
菌落总数(aerobic plate count)就是指在一定条件下(如需氧情况、营养条件、pH、培养温度和时间等)每克(每毫升)检样所生长出来的菌落数。菌落总数测定是用来判定食品被细菌污染的程度及卫生质量,它反映食品在生产过程中是否符合卫生要求,以便对被检样品做出适当的卫生学评价。菌落总数的多少在一定程度上标志着食品卫生质量的优劣。
食品行业目前现行的菌落总数测定标准:《GB 4789.2-2016 食品安全国家标准 食品微生物学检验 菌落总数测定》
二、菌落总数不合格的风险●●
食用菌落总数超标的食品,可能会引起急性中毒、呕吐、腹泻等症状,危害人体健康安全。
三、菌落总数不合格的原因和对策刚分析●●
菌落总数超标的原因及其解决方案有哪些呢?下面我们就从六个方面角度来逐个分析。
一、人员
食品生产运输销售的各个环节员工的不正确行为都有可能导致菌落总数超标,而其中较为普遍的可能为:
1、负责清洗消毒工作的人员对清洗消毒的频率及要求执行不到位或不了解,可能出现生产环境卫生状况不良,生产设备连续使用未进行清洗消毒,对生产设备清洗不干净或消毒不严,产生微生物滞留和滋生等情况造成食品污染,进而导致菌落总数超标。
2、生产操作人员不按生产要求进行操作。如负责杀菌工序的人员对杀菌的参数及要求执行不到位或不了解,可能导致杀菌不彻底。
3、员工培训不到位,缺乏卫生意识。如加工过程中生熟不分发生交叉污染,进而导致菌落总数超标。
在我看来,想要彻底解决人的因素导致菌落总数超标,方法就是培训、培训、再培训!只有通过不断的培训,提高员工的卫生意识及操作规范性才有可能达到我们想要的效果。
二、设备
设备设施的能力和状态也可能与菌落总数超标有关。此处我们以杀菌设备和包装机为例。
包装后需进行杀菌的产品,若杀菌设备性能不足、温度计未校准导致杀菌不彻底都有可能引起菌落总数超标。针对杀菌设备,我们可以通过做热力分布和热穿透测试,验证杀菌釜的性能以及定期使用温度记录仪,跟踪杀菌过程产品温度的变化、做好温度计的校准等工作来避免菌落总数超标。
同样的,包装机若密封性能不足,可能导致产品在杀菌和后期的贮存过程中出现被污染的情况。针对包装机,我们可以通过建立包装机性能验证,确保密封性良好,同时做好内包车间和包装机的清洁卫生来减少菌落总数超标的可能。
三 、物料
物料主要包括各种原辅料、内包材、生产用水和冰等,若各种料原始微生物含量较高,还是有增加后期产品菌落总数超标的风险;因此我们应有针对性的对原辅料包材进行评估,制定一定的验收要求并对原辅料包材进行对应的检测,并在贮存和加工过程中做好温湿度控制和环境管理。
另外,内包材在使用前还可考虑采取紫外灯或臭氧进行消毒。对于生产用水和冰,可以采取每周一次的频率对其微生物状况进行验证。
四、方法
方法主要指的各种有关微生物措施制定的合理性。如,设备设施、环境、人员清洗消毒的频率及方法是否合理?杀菌公式的设定是否合理?生产过程中环境温湿度的控制是否合理?食品储存和运输中设定的条件(如冷链)是否合理等。
这种情况,我们可以采取的措施就是验证。通过对事前事后进行微生物实验,将得出的数据进行比对,确认方法是否可行。除此之外,我们还可以通过调整一定的参数并采集实验数据来对方法进行优化,进而确定最合适的方法。
五、环境
从原辅料的运输、贮存、加工成成品以及销售等各个环节场所的不当,都有可能导致产品菌落总数超标。如包装车间卫生不当、生产环境温湿度控制不当、废料间卫生间位置设施不当等等。
针对环境,我们可以采取的措施是合理考虑各个场所的布局、严格控制各个环节的温湿度以及持续保持各个场所的卫生等。
六、流通
若在流通环节检出多种食品存在菌落总数超标的情况,则问题极有可能是销售方未按照规定要求存储、摆放食品,比如个别超市不具备低温冷藏设施却销售需冷藏的食品,有的食品标签标注储存条件为避光,销售者却将食品置于阳光直射条件下等。
四、小结●●
1)作为消费者,应选购在保质期内、包装完整、形状正常的食品。不要购买三无产品。如果是熟制加工食品,则需烧熟煮透并且按照正确的温度方法保存。发现购买的食品出现质量安全问题时,应及时向当地消费者协会或相关监管部门反映或投诉维护自己的合法权益。
2)作为生产企业,应对产品原材料进行严格把关,做到不进购、不使用过期或者不新鲜的原材料。对于生产加工环境,要区分清洁区与非清洁区,做好防鼠防虫等工作。同时要加强食品从业人员的食品安全意识,提高卫生管理要求。
3)使用微生物测试片可以快速检测食品和饮料中微生物受污染程度,详情可了解小编之前发布的文章《卫生指示菌(菌落总数、大肠菌群、霉菌酵母总数)快检方案 —— 微生物检测片法》
